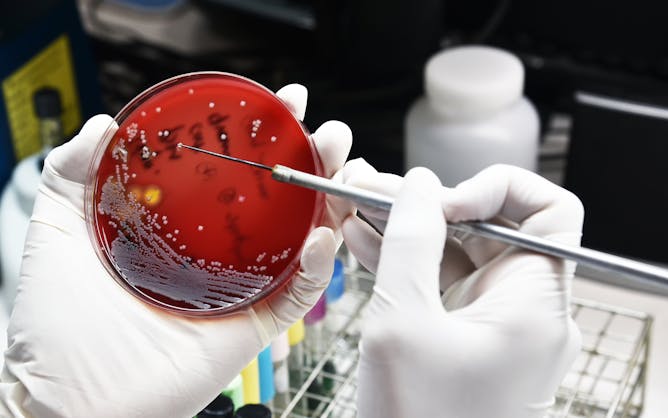

|
The rise of drug-resistant infections is one of the biggest global threats to health, food security and development. Antibiotic-resistant superbugs were estimated to kill 1.27 million people in 2019, and the UN projects that drug-resistant diseases could cause 10 million deaths a year by 2050.
In this episode of The Conversation Weekly podcast, we hear from Fron Jackson-Webb, Deputy Editor and Senior Health Editor of our Australian edition, about the issue and some of the experts she has commissioned as part of a special series. We also speak to a microbiologist at a hospital in Nigeria working on the frontlines against antibiotic resistance, and find out about the new scientific techniques, including
artificial intelligence (AI), being deployed to find new potential antibiotics.
|
Testing for antimicrobial resistance in the lab.
AnaLysiSStudiO via Shutterstock
Gemma Ware, The Conversation
From the frontline battle against antibiotic resistance in Nigeria, to the techniques being used to find new antibiotics. Listen to The Conversation Weekly podcast.
|

The music room of the Ospedaletto is known for its remarkable acoustics.
Marica S. Tacconi
Marica S. Tacconi, Penn State
On the wall of an orphanage in Venice, a musicologist encountered a fresco featuring an aria written for an opera. She’s since embarked on a project to bring this forgotten music back.
|

Joaquin Phoenix as Napoleon.
Courtesy of Apple
Joan Tumblety, University of Southampton
Here are the truths behind some of the major scenes from Ridley Scott’s new Napoleon biopic.
|
|
|
-
Kavita Babu, UMass Chan Medical School
Fentanyl’s wide availability in the drug supply has led to an increase in unintentional overdoses. While prevention strategies are available, limited availability stymies their use.
-
María Luz Martínez Alarcón, Universidad de Castilla-La Mancha
Pedro Sánchez is offering Catalan separatist Carles Puigdemont amnesty for his role in illegal independence referendums in 2014 and 2017.
-
Omololu Fagunwa, Queen's University Belfast; Helen Onyeaka, University of Birmingham
The struggle with open defecation is a silent emergency, undermining the continent’s efforts towards sustainable development goals.
-
Jason W. Osborne, Miami University
The rise of sports betting has made gambling addiction a bigger issue on college campuses, but there are steps universities can take to address it.
-
Derryck Telford Reid, Heriot-Watt University
From improving our understanding of dark matter to revealing the location of Earth 2.0, the Extremely Large Telescope promises answers to some of the biggest scientific questions of our time.
-
Giselle Bastin, Flinders University
When The Crown debuted in 2016, the quality of the story lines, acting and impressive production standards were striking. What happened?
-
Gwen Ansell, University of Pretoria
A 26-member theatre ensemble aims to bring history to light in a fresh way.
-
Angeline Close Scheinbaum, Clemson University
Of course the NFL is embracing Taylor Swift.
-
John Valentine, MacEwan University
While the Grey Cup and Canadian football were once considered significant national institutions, part of their allure appears to have faded over the years.
|
|